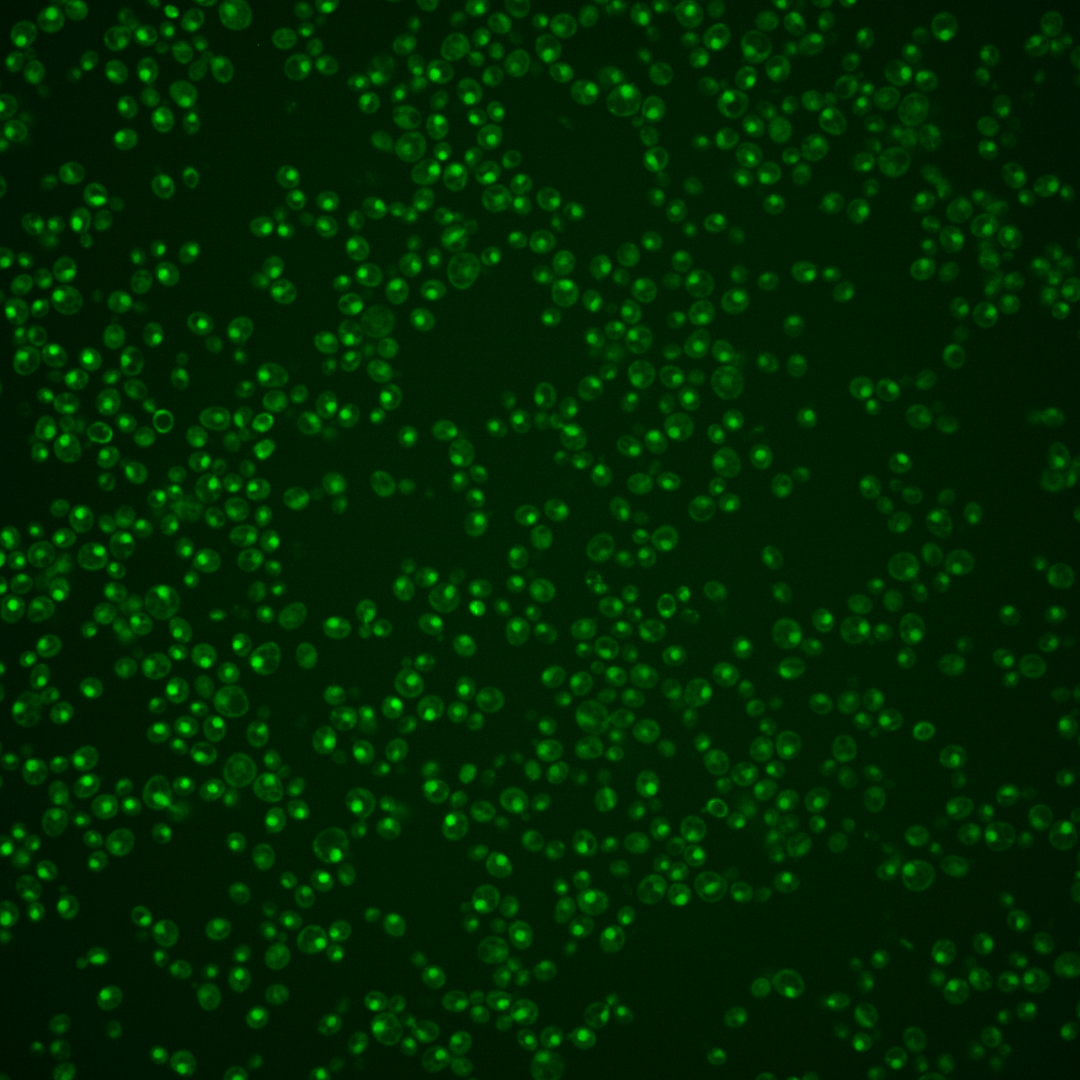
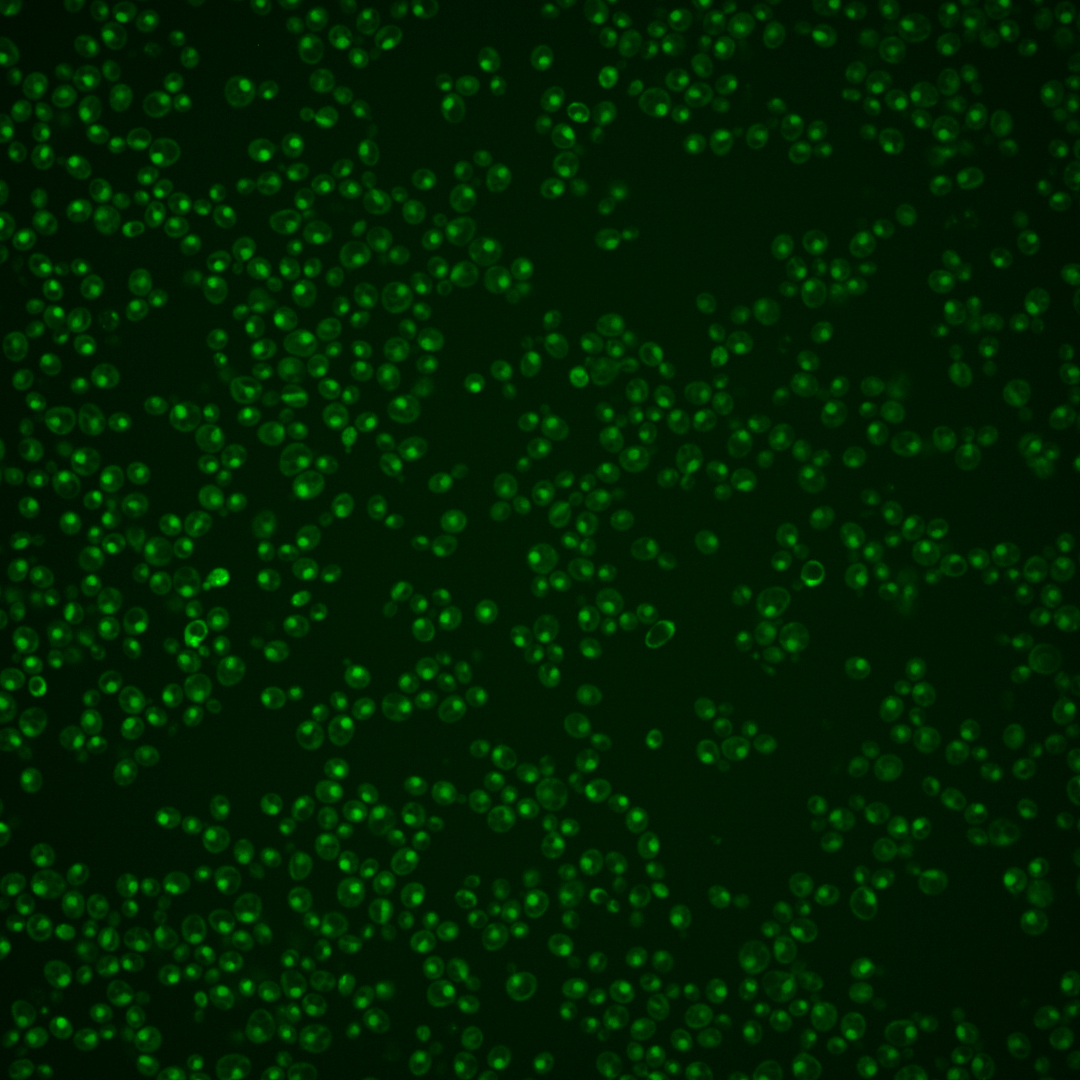

| Standard name | |
|---|---|
| Human Ortholog | |
| Description | Member of the NineTeen Complex (NTC); NTC contains Prp19p and stabilizes U6 snRNA in catalytic forms of spliceosome containing U2, U5, and U6 snRNAs; interacts with Prp16p to modulate splicing fidelity; isy1 syf2 cells have defective spindles |
Micrographs




















































































Sub-cellular Localization
Yeast GFP Assignment
Protein Abundance
Localization Change
External localization resources
| ensLOC | DeepLoc | |||||||||||||||||||||||
|---|---|---|---|---|---|---|---|---|---|---|---|---|---|---|---|---|---|---|---|---|---|---|---|---|
| Localization | WT1 | WT2 | WT3 | RAP60 | RAP140 | RAP220 | RAP300 | RAP380 | RAP460 | RAP540 | RAP620 | RAP700 | HU80 | HU120 | HU160 | rpd3Δ_1 | rpd3Δ_2 | rpd3Δ_3 | WT1 | WT2 | WT3 | AF100 | AF140 | AF180 |
| Cortical Patches | 0 | 0 | 0 | 0 | 0 | 0 | 0 | – | 0 | 0 | 1 | 0 | 0 | 0 | 0 | 0 | 0 | 0 | 0 | 0 | 0 | 0 | 0 | 0 |
| Bud | 0 | 0 | 0 | 0 | 0 | 5 | 0 | – | 2 | 8 | 5 | 5 | 0 | 0 | 0 | 1 | 0 | 1 | 1 | 0 | 1 | 1 | 3 | 5 |
| Bud Neck | 0 | 0 | 0 | 0 | 0 | 0 | 1 | – | 1 | 2 | 0 | 1 | 0 | 0 | 0 | 0 | 0 | 0 | 0 | 0 | 0 | 0 | 0 | 0 |
| Bud Site | 1 | 0 | 0 | 0 | 0 | 11 | 1 | – | 6 | 11 | 17 | 26 | 0 | 0 | 0 | 0 | 0 | 0 | – | – | – | – | – | – |
| Cell Periphery | 0 | 0 | 0 | 0 | 0 | 0 | 1 | – | 0 | 0 | 1 | 0 | 0 | 1 | 0 | 0 | 1 | 0 | 0 | 0 | 0 | 0 | 0 | 0 |
| Cytoplasm | 8 | 5 | 11 | 13 | 14 | 26 | 32 | – | 21 | 31 | 20 | 30 | 23 | 56 | 66 | 22 | 16 | 12 | 1 | 0 | 2 | 0 | 1 | 2 |
| Endoplasmic Reticulum | 0 | 0 | 1 | 0 | 0 | 1 | 0 | – | 0 | 0 | 0 | 0 | 0 | 1 | 1 | 3 | 2 | 1 | 0 | 0 | 0 | 0 | 1 | 2 |
| Endosome | 0 | 0 | 0 | 0 | 0 | 0 | 2 | – | 0 | 1 | 0 | 3 | 0 | 2 | 4 | 2 | 5 | 0 | 5 | 0 | 0 | 3 | 3 | 3 |
| Golgi | 0 | 0 | 0 | 0 | 0 | 0 | 0 | – | 0 | 0 | 0 | 0 | 0 | 1 | 1 | 0 | 1 | 1 | 0 | 0 | 0 | 0 | 0 | 1 |
| Mitochondria | 19 | 12 | 2 | 5 | 8 | 106 | 36 | – | 125 | 99 | 166 | 169 | 2 | 0 | 0 | 3 | 6 | 6 | 2 | 0 | 3 | 0 | 4 | 6 |
| Nucleus | 170 | 237 | 272 | 142 | 149 | 199 | 306 | – | 231 | 240 | 316 | 418 | 284 | 284 | 293 | 107 | 162 | 184 | 169 | 232 | 260 | 152 | 232 | 149 |
| Nuclear Periphery | 1 | 0 | 0 | 3 | 1 | 1 | 0 | – | 4 | 2 | 3 | 6 | 0 | 2 | 1 | 1 | 5 | 1 | 0 | 0 | 1 | 1 | 0 | 1 |
| Nucleolus | 14 | 2 | 0 | 0 | 0 | 0 | 1 | – | 8 | 8 | 10 | 8 | 0 | 0 | 2 | 1 | 0 | 3 | 4 | 2 | 2 | 9 | 16 | 17 |
| Peroxisomes | 0 | 0 | 0 | 0 | 0 | 0 | 0 | – | 0 | 0 | 0 | 0 | 0 | 1 | 5 | 0 | 1 | 0 | 0 | 0 | 0 | 0 | 0 | 0 |
| SpindlePole | 0 | 1 | 9 | 0 | 1 | 2 | 6 | – | 3 | 5 | 5 | 7 | 0 | 2 | 2 | 0 | 3 | 0 | 4 | 0 | 1 | 3 | 2 | 3 |
| Vac/Vac Membrane | 2 | 8 | 0 | 1 | 2 | 1 | 10 | – | 4 | 2 | 2 | 7 | 2 | 8 | 16 | 11 | 11 | 12 | 13 | 10 | 16 | 17 | 29 | 42 |
| Unique Cell Count | 190 | 251 | 284 | 155 | 168 | 254 | 364 | 294 | 314 | 395 | 525 | 309 | 348 | 382 | 139 | 197 | 206 | 207 | 249 | 291 | 194 | 300 | 240 | |
| Labelled Cell Count | 215 | 265 | 295 | 164 | 175 | 352 | 396 | 405 | 409 | 546 | 680 | 311 | 358 | 391 | 151 | 213 | 221 | 207 | 249 | 291 | 194 | 300 | 240 | |
Yeast GFP Assignment
Protein Abundance
| Screen | WT1 | WT2 | WT3 | RAP60 | RAP140 | RAP220 | RAP300 | RAP380 | RAP460 | RAP540 | RAP620 | RAP700 | HU80 | HU120 | HU160 | rpd3Δ_1 | rpd3Δ_2 | rpd3Δ_3 | AF100 | AF140 | AF180 |
|---|---|---|---|---|---|---|---|---|---|---|---|---|---|---|---|---|---|---|---|---|---|
| Mean Cell GFP Intensity (1e-4) | 5.3 | 6.0 | 6.0 | 6.0 | 6.0 | 4.0 | 5.2 | – | 4.5 | 4.8 | 4.5 | 4.6 | 6.1 | 6.5 | 6.3 | 8.3 | 7.7 | 8.2 | 5.7 | 5.9 | 6.2 |
| Std Deviation (1e-4) | 0.9 | 0.9 | 1.3 | 1.6 | 1.7 | 1.2 | 1.7 | – | 1.6 | 1.7 | 1.4 | 1.2 | 1.2 | 1.8 | 1.8 | 2.2 | 1.8 | 2.5 | 1.6 | 1.5 | 1.9 |
| Intensity Change (Log2) | – | – | – | -0.01 | 0.0 | -0.6 | -0.22 | – | -0.42 | -0.32 | -0.42 | -0.4 | 0.02 | 0.12 | 0.07 | 0.46 | 0.36 | 0.44 | -0.08 | -0.05 | 0.03 |
Localization Change
| Localization | RAP60 | RAP140 | RAP220 | RAP300 | RAP380 | RAP460 | RAP540 | RAP620 | RAP700 | HU80 | HU120 | HU160 | rpd3Δ_1 | rpd3Δ_2 | rpd3Δ_3 |
|---|---|---|---|---|---|---|---|---|---|---|---|---|---|---|---|
| Cortical Patches | 0 | 0 | 0 | 0 | – | 0 | 0 | 0 | 0 | 0 | 0 | 0 | 0 | 0 | 0 |
| Bud | 0 | 0 | 0 | 0 | – | 0 | 0 | 0 | 0 | 0 | 0 | 0 | 0 | 0 | 0 |
| Bud Neck | 0 | 0 | 0 | 0 | – | 0 | 0 | 0 | 0 | 0 | 0 | 0 | 0 | 0 | 0 |
| Bud Site | 0 | 0 | 0 | 0 | – | 0 | 0 | 0 | 0 | 0 | 0 | 0 | 0 | 0 | 0 |
| Cell Periphery | 0 | 0 | 0 | 0 | – | 0 | 0 | 0 | 0 | 0 | 0 | 0 | 0 | 0 | 0 |
| Cytoplasm | 2.0 | 2.0 | 2.9 | 2.5 | – | 1.7 | 2.9 | 0.7 | 1.1 | 1.9 | 5.0 | 5.4 | 4.3 | 2.0 | 1.0 |
| Endoplasmic Reticulum | 0 | 0 | 0 | 0 | – | 0 | 0 | 0 | 0 | 0 | 0 | 0 | 0 | 0 | 0 |
| Endosome | 0 | 0 | 0 | 0 | – | 0 | 0 | 0 | 0 | 0 | 0 | 0 | 0 | 0 | 0 |
| Golgi | 0 | 0 | 0 | 0 | – | 0 | 0 | 0 | 0 | 0 | 0 | 0 | 0 | 0 | 0 |
| Mitochondria | 0 | 0 | 0 | 4.9 | – | 0 | 0 | 0 | 0 | 0 | 0 | 0 | 0 | 0 | 0 |
| Nucleus | -1.8 | -2.9 | -6.1 | -4.8 | – | -6.2 | -6.7 | -6.0 | -6.2 | -1.9 | -5.4 | -6.8 | -5.9 | -4.9 | -2.8 |
| Nuclear Periphery | 0 | 0 | 0 | 0 | – | 0 | 0 | 0 | 0 | 0 | 0 | 0 | 0 | 0 | 0 |
| Nucleolus | 0 | 0 | 0 | 0 | – | 0 | 0 | 0 | 0 | 0 | 0 | 0 | 0 | 0 | 0 |
| Peroxisomes | 0 | 0 | 0 | 0 | – | 0 | 0 | 0 | 0 | 0 | 0 | 0 | 0 | 0 | 0 |
| SpindlePole | 0 | 0 | 0 | -1.3 | – | 0 | 0 | 0 | 0 | 0 | 0 | 0 | 0 | 0 | 0 |
| Vacuole | 0 | 0 | 0 | 0 | – | 0 | 0 | 0 | 0 | 0 | 0 | 3.5 | 0 | 0 | 4.1 |
External localization resources
Images






























Protein Concentration and Protein Localization Data
| R1 | R2 | R3 | ||||||||||||||||
|---|---|---|---|---|---|---|---|---|---|---|---|---|---|---|---|---|---|---|
| G1 Pre-START | G1 Post-START | S/G2 | Metaphase | Anaphase | Telophase | G1 Pre-START | G1 Post-START | S/G2 | Metaphase | Anaphase | Telophase | G1 Pre-START | G1 Post-START | S/G2 | Metaphase | Anaphase | Telophase | |
| Concentration | 0.223 | 0.1663 | -0.0054 | -0.2183 | -0.408 | 0.0397 | 2.0644 | 1.7956 | 1.5974 | 1.3416 | 1.2517 | 1.7331 | 4.5449 | 5.0127 | 4.6015 | 4.4133 | 4.1341 | 4.4944 |
| Actin | 0.0135 | 0 | 0.0012 | 0 | 0.0001 | 0.0007 | 0.0054 | 0 | 0.0019 | 0.0304 | 0.0147 | 0.0065 | 0 | 0 | 0 | 0 | 0.0012 | 0 |
| Bud | 0.0003 | 0 | 0.0001 | 0 | 0.0001 | 0 | 0.0005 | 0 | 0.0005 | 0.0016 | 0.0001 | 0.0002 | 0 | 0 | 0 | 0 | 0.0003 | 0 |
| Bud Neck | 0.0021 | 0 | 0.0007 | 0 | 0.0002 | 0.0008 | 0.0023 | 0 | 0.0012 | 0.0031 | 0.0011 | 0.0014 | 0.0002 | 0.0001 | 0 | 0 | 0.001 | 0.0005 |
| Bud Periphery | 0.0012 | 0 | 0.0002 | 0 | 0.0001 | 0.0001 | 0.001 | 0 | 0.0007 | 0.0038 | 0.0003 | 0.0008 | 0 | 0 | 0 | 0 | 0.0006 | 0 |
| Bud Site | 0.0004 | 0 | 0.0001 | 0 | 0.0002 | 0.0001 | 0.0043 | 0 | 0.0035 | 0.002 | 0.0003 | 0.0003 | 0.0001 | 0 | 0 | 0 | 0.0006 | 0 |
| Cell Periphery | 0.0002 | 0 | 0.0001 | 0 | 0 | 0 | 0.0008 | 0 | 0.0003 | 0.0001 | 0 | 0.0001 | 0 | 0 | 0 | 0 | 0.0001 | 0 |
| Cytoplasm | 0.0018 | 0.0002 | 0.001 | 0.0001 | 0.0037 | 0.0006 | 0.0073 | 0.0031 | 0.0019 | 0.0003 | 0.0002 | 0.0004 | 0.0004 | 0.001 | 0.0004 | 0.0003 | 0.0024 | 0.0002 |
| Cytoplasmic Foci | 0.0026 | 0 | 0.0005 | 0 | 0.0034 | 0.0019 | 0.0168 | 0.0002 | 0.0019 | 0.0051 | 0.0041 | 0.0014 | 0.0005 | 0 | 0 | 0 | 0.0034 | 0 |
| Eisosomes | 0.0002 | 0 | 0.0001 | 0 | 0 | 0 | 0.0001 | 0 | 0.0001 | 0.0002 | 0.0001 | 0 | 0 | 0 | 0 | 0 | 0 | 0 |
| Endoplasmic Reticulum | 0.0014 | 0 | 0.0005 | 0 | 0.0004 | 0.0003 | 0.0026 | 0.0002 | 0.001 | 0.0001 | 0.0005 | 0.0011 | 0.0001 | 0 | 0 | 0 | 0.0012 | 0 |
| Endosome | 0.0143 | 0 | 0.0005 | 0 | 0.0265 | 0.0036 | 0.0298 | 0.0002 | 0.0095 | 0.002 | 0.0031 | 0.0081 | 0.0006 | 0 | 0 | 0 | 0.0036 | 0 |
| Golgi | 0.0031 | 0 | 0.0003 | 0 | 0.0014 | 0.0007 | 0.012 | 0 | 0.0025 | 0.003 | 0.0036 | 0.0063 | 0.0001 | 0 | 0 | 0 | 0.0006 | 0 |
| Lipid Particles | 0.0048 | 0 | 0.0056 | 0 | 0.0005 | 0.005 | 0.0478 | 0 | 0.0016 | 0.0041 | 0.0195 | 0.0007 | 0.0004 | 0 | 0 | 0 | 0.0007 | 0 |
| Mitochondria | 0.0051 | 0.0002 | 0.004 | 0 | 0.0014 | 0.001 | 0.0152 | 0.0001 | 0.0051 | 0.0155 | 0.0072 | 0.0109 | 0.0001 | 0.0001 | 0.0001 | 0 | 0.0009 | 0 |
| None | 0.0021 | 0 | 0.0004 | 0 | 0.0016 | 0.0003 | 0.0012 | 0.004 | 0.0014 | 0.0005 | 0.0001 | 0.0001 | 0.0011 | 0.0012 | 0.0053 | 0.0003 | 0.0004 | 0 |
| Nuclear Periphery | 0.0179 | 0.0105 | 0.008 | 0.0008 | 0.0244 | 0.007 | 0.0272 | 0.0047 | 0.0125 | 0.0008 | 0.0253 | 0.0083 | 0.0013 | 0.0028 | 0.0012 | 0.0006 | 0.0026 | 0.0004 |
| Nucleolus | 0.0111 | 0.0063 | 0.005 | 0.0023 | 0.0195 | 0.0195 | 0.0205 | 0.0049 | 0.0052 | 0.0024 | 0.0305 | 0.0247 | 0.0068 | 0.0062 | 0.0044 | 0.0033 | 0.0134 | 0.0168 |
| Nucleus | 0.9053 | 0.9819 | 0.9682 | 0.9965 | 0.9105 | 0.9507 | 0.7711 | 0.9808 | 0.941 | 0.9133 | 0.8442 | 0.9185 | 0.9833 | 0.9838 | 0.9877 | 0.9941 | 0.9612 | 0.9806 |
| Peroxisomes | 0.0008 | 0 | 0.0011 | 0 | 0.0003 | 0.0011 | 0.0117 | 0 | 0.0005 | 0.0094 | 0.0217 | 0.0023 | 0.0001 | 0 | 0 | 0 | 0.0005 | 0 |
| Punctate Nuclear | 0.0077 | 0.0007 | 0.0016 | 0.0001 | 0.0031 | 0.0058 | 0.0121 | 0.0015 | 0.0025 | 0.0018 | 0.0215 | 0.0046 | 0.0047 | 0.0044 | 0.0007 | 0.0012 | 0.0042 | 0.0013 |
| Vacuole | 0.0024 | 0 | 0.0005 | 0 | 0.0018 | 0.0004 | 0.0079 | 0.0001 | 0.0036 | 0.0002 | 0.0007 | 0.0016 | 0.0002 | 0.0001 | 0 | 0 | 0.001 | 0 |
| Vacuole Periphery | 0.0017 | 0.0001 | 0.0003 | 0 | 0.0009 | 0.0003 | 0.0026 | 0 | 0.0015 | 0.0002 | 0.0013 | 0.0013 | 0 | 0 | 0 | 0 | 0.0002 | 0 |
Sequencing Data
| R1 | R2 | |||||||||
|---|---|---|---|---|---|---|---|---|---|---|
| G1 Post-START | S/G2 | Metaphase | Anaphase | Telophase | G1 Post-START | S/G2 | Metaphase | Anaphase | Telophase | |
| Gene Expression | 8.5716 | 11.1455 | 12.4057 | 15.2617 | 13.1342 | 23.3643 | 15.8473 | 10.4582 | 16.6254 | 14.4999 |
| Translational Efficiency | 3.0542 | 1.5844 | 1.709 | 1.7249 | 1.7603 | 1.0331 | 1.3567 | 2.0807 | 1.4823 | 1.5917 |
Hit Data
| Dataset | Hit |
|---|---|
| Protein Concentration | ✘ |
| Protein Localization | ✘ |
| Gene Expression | ✘ |
| Translational Efficiency | ✘ |
Endocytosis
| Temp | Actin Patch (Sac6-tdTomato) | Cortical Patch (Sla1-GFP) | Late Endosome (Snf7-GFP) | Vacuole (Vph1-GFP) |
|---|---|---|---|---|
| 37℃ | ||||
| RT |
Cell Cycle Omics
CYCLoPs (Isy1-GFP)
| Gene / Allele | Actin Patch (Sac6-tdTomato) | Cortical Patch (Sla1-GFP) | Late Endosome (Snf7-GFP) | Vacuole (Sac6-tdTomato) |
|---|
| Gene | Images |
|---|
| Gene | Images |
|---|
Images are not yet available
Images are not yet available